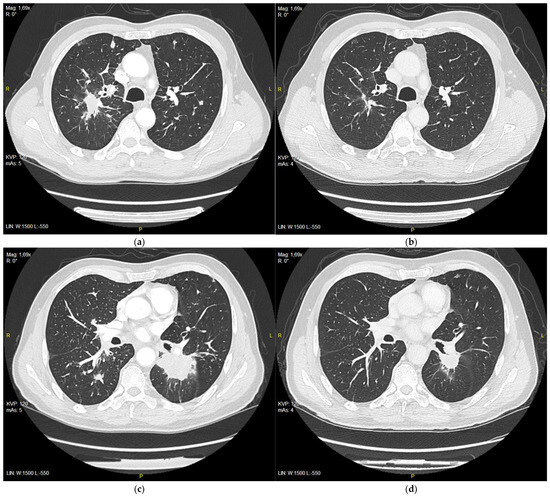

マイストア
変更
お店で受け取る
(送料無料)
配送する
納期目安:
2025.09.07 2:50頃のお届け予定です。
決済方法が、クレジット、代金引換の場合に限ります。その他の決済方法の場合はこちらをご確認ください。
※土・日・祝日の注文の場合や在庫状況によって、商品のお届けにお時間をいただく場合がございます。
健康・医学 PCR/RT-PCRinsituLight&ElectronMicroscopy EZ-SARS-CoV-2 Real-Time RT-PCR Test - Tetracore, Inc.の詳細情報
EZ-SARS-CoV-2 Real-Time RT-PCR Test - Tetracore, Inc.。健康・医学 PCR/RT-PCRinsituLight&ElectronMicroscopy SARS-CoV。A molecular test based on RT-LAMP for rapid, sensitive and。PCR/RT- PCR in situ Light and Electron MicroscopyBy Mireille RaccurtCopyright Year 2002ISBN 9780849300417Published September 27, 2002 by CRC Press432 Pages 21 Color & 237 B/W Illustrationsご覧いただきありがとうございます。Full article: RT-LAMP in SARS-CoV-2 detection: point to。ご検討いただけますと幸いです。現時点最新版⚠️裁断済み⚠️スタンダード パーシャルデンチャー 補綴学 第4版。何卒よろしくお願いいたします。パーフェクト 人工膝関節置換術。
ベストセラーランキングです
近くの売り場の商品
カスタマーレビュー
オススメ度 4.6点
現在、3236件のレビューが投稿されています。